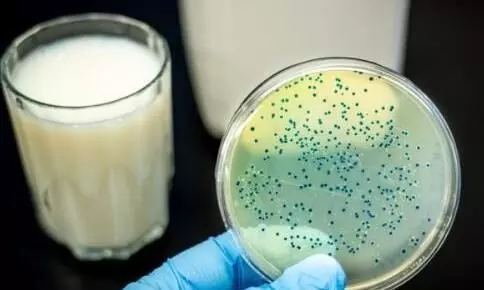
poison in milk poison in milk

പാലിൽ മാരകവിഷം; ഫലപ്രദ നടപടിയെടുക്കാതെ ഉദ്യോഗസ്ഥർ
text_fieldsതിരുവനന്തപുരം: മനുഷ്യശരീരത്തിന് ഹാനികരമാകുന്ന വിഷപദാർഥങ്ങൾ പാലിൽ കലർത്തുന്നെന്ന് ക്ഷീരവികസ വകുപ്പിന് കീഴിലെ ഡെയറി ലാബുകളിൽ നടത്തിയ പരിശോധനയിൽ കണ്ടെത്തി. യൂറിയ, മാൽറ്റോ ഡെക്സ്ട്രിൻ എന്നീ രാസവസ്തുക്കളാണ് പാലിൽ ചേർക്കുന്നത്. 2021 ഡിസംബർ ഒന്നുമുതൽ 2022 നവംബർ 30വരെ ചെക്പോസ്റ്റുകളോട് ചേർന്നുള്ള ലാബുകളിൽ നടത്തിയ പരിശോധനയിലാണ് ഞെട്ടിപ്പിക്കുന്ന കണ്ടെത്തൽ. വിവരാവകാശ നിയമപ്രകാരം രാജു വാഴക്കാലക്ക് ക്ഷീരവികസന വകുപ്പിൽനിന്ന് ലഭിച്ച രേഖയിലാണ് ഇക്കാര്യമുള്ളത്.
കേരളത്തിൽ ഒരുദിവസം ശരാശരി 91.4 ലക്ഷം ലിറ്റർ പാലാണ് ചെലവാകുന്നത്. ഇതിൽ 75 ശതമാനവും പുറത്തുനിന്ന് എത്തിക്കുന്നതാണ്. ഇതരസംസ്ഥാനങ്ങളിൽനിന്ന് ടാങ്കറുകളിലും പാക്കറ്റുകളായും എത്തിക്കുന്ന പാൽ പരിശോധിച്ചപ്പോഴാണ് വിഷപദാർഥങ്ങൾ ചേർക്കുന്നതായി കണ്ടെത്തിയത്. ഇക്കാര്യം ബന്ധപ്പെട്ട വകുപ്പുകളുടെ ശ്രദ്ധയിൽപെട്ടിട്ടും മായം കലർന്ന പാൽ എത്തുന്നത് തടയാൻ അധികൃതർ ഫലപ്രദമായ നടപടി സ്വീകരിക്കുന്നില്ലെന്നാണ് വ്യക്തമാകുന്നത്. തമിഴ്നാട്ടില്നിന്ന് കേരളത്തിലെത്തിച്ച മായം കലര്ന്ന പാൽ കഴിഞ്ഞമാസം സംസ്ഥാനാതിര്ത്തികളില് പിടികൂടിയിരുന്നു. ക്ഷീരവികസന വകുപ്പ് പിടിച്ചെടുത്ത 15,300 ലിറ്റര് പാലിൽ പ്രാഥമിക പരിശോധനയിൽ ഹൈഡ്രജൻ പെറോക്സൈഡിന്റെ സാന്നിധ്യം കണ്ടെത്തി.
പാലക്കാട് മീനാക്ഷിപുരം, കൊല്ലം ആര്യങ്കാവ്, തിരുവനന്തപുരം പാറശ്ശാല എന്നിവിടങ്ങളിലെ ചെക്പോസ്റ്റുകൾ കടന്നാണ് കേരളത്തിലേക്ക് പാൽ എത്തുന്നത്. അഞ്ചുമുതൽ ആറുലക്ഷം ലിറ്റർ പാൽ ഒരു ദിവസം അതിർത്തി കടന്ന് എത്തുന്നെന്നാണ് കണക്ക്.
Don't miss the exclusive news, Stay updated
Subscribe to our Newsletter
By subscribing you agree to our Terms & Conditions.